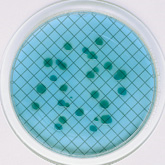

Поиск по сайту
Фраза для поиска:





























Бульон: Pseudomonas Broth, Pseudomonas sp., 2 мл, пластик (50 шт. в уп.)
Бульон Pseudomonas является высокоселективной средой для определения организмов рода Pseudomonas sp., и используются для мониторинга образцов везде, где необходимо предотвратить загрязнение этими организмами.
Характерным свойством Pseudomonas aeruginosa является образование пиоцианина - сине-зеленого, водорастворимого нефлуоресцентного пигмента феназиновой природы, которое стимулируется добавлением к среде хлорида магния и сульфата калия. Иргазан, антимикробный агент, избирательно подавляет грамположительные и грамотрицательные бактерии, не относящиеся к роду Рseudomonas. Глицерин служит источником энергии, а также способствует образованию пиоцианина.
Бульон Pseudomonas, P. Aeruginosa 48 ч. Т=35 °C